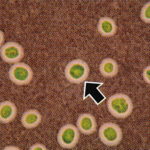

バイオリンク 7つの特徴
①バイオリンクは、チクゴ株クロレラ100%です。
クロレラの他のメーカーのなかには、粒の形に固めるために、添加物などを使つているものもあるようですが、クロレラ工業製のバイオリンクは、添加物や着色料はいっさい使用しておりません。
その理由は、バイオリンクの原料であるチクゴ株クロレラは、「多糖体」を細胞周囲に分泌しているため、それが細胞同士をくつつけるため、チクゴ株クロレラだけで粒状にすることが可能なのです。

バイオリンクー粒には、約20億個のチクゴ株クロレラだけが、ぎゅっと詰まつています。
② バイオリンクには、特有の成分・クロレラエキス(BCEx)が含まれています。
バイオリンクには、BCExというチクゴ株クロレラに特有のクロレラエキスが平均約35%(HTHP法)注1含まれています。このBCExは、糖たん自、多糖体、核酸関連物質が主成分です。
そして、このBCExは、「人間の体に元々そなわっている、自分の体を常に健康に保とうとする力」に役立つことが解明されています。
注1)HTHP法:クロレラ細胞から有用成分を効率よく抽出・測定できる方法で水高温高圧抽出法といいます。 (High Temperature & High Pressure water extract method)
③バイオリンクは、他のクロレラに比べて大変「消化」されやすいです。

クロレラには「細胞壁」という殻のような部分があり、細胞の中身を保護しています。しかし、この細胞壁は胃や腸での消化を妨げるため、クロレラ製品を食べても思つたほど消化されません。
バイオリンクは、細胞壁が薄いチクゴ株クロレラを使つているため、82%という高い消化率を実現しています。

④バイオリンクは、安全・安心です。
バイオリンクに使われるチクゴ株クロレラは、非常に厳しいクロレラ工業(株)の規格基準のもとで商品化されています。
製造面においても、徹底した品質管理のもと、すべて福岡県筑後市にあるクロレラ工業(株)の工場内で一貫して行なわれています。もちろん、公的機関による安全性試験についても、パスしております。
⑤バイオリンクは、研究豊富なクロレラの専門企業から生まれました。
クロレラ工業(株)は、より高品質・高価値の商品をお届けできるよう、日々クロレラの研究を続けています。その一例として、社内にはクロレラの研究で博士号を取得した”いわゆる「クロレラ博士」”がいます。さらに、会社内だけではなく、全国の病院・大学・公共機関との共同研究も、1964年の創業以来、積極的に取り組んでいます。
その成果として、いままでに医学・薬学・栄養学の各学会で発表したデータは400例以上となります。これは健康食品業界においても類を見ない実績です。
⑥バイオリンクは、太陽の光を十分に吸収したチクゴ株クロレラです。
クロレラは、太陽光によって光合成を行ない、細胞内の成分を充実させていきます。その際に大切なことは、光の強さではなく、クロレラの細胞一つひとつが十分に光を吸収 できることです。
クロレラ工業(株)の工場では、水深15cmという浅いプールでチクゴ株の培養を行なっているため、太陽光をたつぷりと吸収し栄養成分やクロレラエキス(BCEx)が充実しています。
⑦バイオリンクは、健康相談の専門家がお勧めする、しかも新鮮な商品です。
バイオリンクは、地域に密着している健康相談の専門家である「相談薬局・薬店」が責任を持つて販売しています。また、商品自体についても、お客さまのお手元に、新鮮なままお届け出来るよう「インナーシール」を採用し、さらに脱酸素剤を入れてしっかりと密閉させ、作りたての新鮮さを販売しています。





